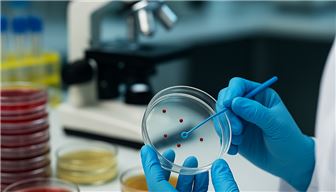

Woodstock, GA
This opportunity is structured as a junior partnership with a three-month minimum transition period to full ownership, with a 25% down payment. The new owner will work alongside the current...

Woodstock, GA
This opportunity is structured as a junior partnership with a three-month minimum transition period to full ownership, with a 25% down payment. The new owner will work alongside the current...
$180,000
$180,000
Cash Flow: $94,321
Georgia
Established in 2008, this FDA-registered, DEA-registered, GMP-compliant laboratory provides high-precision analytical chemistry and microbiology testing services to pharmaceuticals, cosmetics,...
$1,500,000
$1,500,000
Cash Flow: $374,000